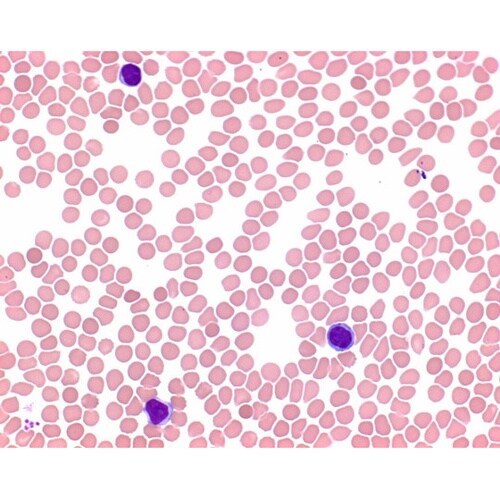
1.01424.0503 メイ−グリュン

分析/検査用品(その他)の売れ筋ランキング
- ¥4,510(税込) (税込) 〜
- ¥1,881(税込) (税込) 〜
- ¥1,430(税込) (税込) 〜
- ¥3,487(税込) (税込) 〜
- ¥12,540(税込) (税込) 〜
- ¥3,366(税込) (税込) 〜
- ¥25,080(税込) (税込) 〜
商品仕様 |
|
|---|---|
メーカー情報 |
|
カタログ掲載ページ |
-/- |
| 注意事項 | ※【お届けに関するご注意】この商品は、画面に表示されているお届け予定日までにお届けいたします。実際のお届けが、予定日よりも早まる場合がございます。 |
|---|